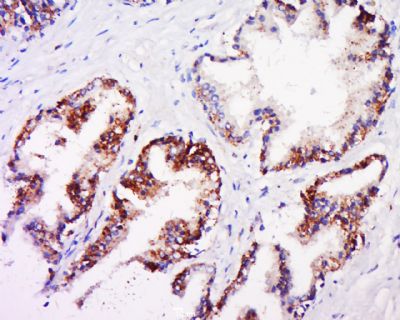

产品中心
当前位置:首页>产品中心Anti-phospho-Androgen Receptor (Ser578)
货号: bs-0943R 基本售价: 1580.0 元 规格: 100ul
产品信息
- 产品编号
- bs-0943R
- 英文名称
- phospho-Androgen Receptor (Ser578)
- 中文名称
- 磷酸化雄激素受体抗体
- 别 名
- AIS; AIS; ANDR_HUMAN; Androgen receptor (dihydrotestosterone receptor; testicular feminization; spinal and bulbar muscular atrophy; Kennedy disease); Androgen receptor; AR; DHTR; Dihydro Testosterone Receptor; Dihydrotestosterone receptor; HUMARA; HYSP1; HYSP1; KD; NR3C4; Nuclear receptor subfamily 3 group C member 4; SBMA; SMAX1; Spinal and bulbar muscular atrophy; TFM.
- 规格价格
- 100ul/1580元购买 大包装/询价
- 说 明 书
- 100ul
- 产品类型
- 磷酸化抗体
- 研究领域
- 肿瘤 免疫学 信号转导 细胞凋亡 转录调节因子
- 抗体来源
- Rabbit
- 克隆类型
- Polyclonal
- 交叉反应
- Human, Mouse, Rat, Chicken, Dog, Pig, Cow, Horse,
- 产品应用
- WB=1:500-2000 ELISA=1:500-1000 IHC-P=1:400-800 IHC-F=1:400-800 Flow-Cyt=3ug/Test IF=1:100-500 (石蜡切片需做抗原修复)
not yet tested in other applications.
optimal dilutions/concentrations should be determined by the end user.
- 分 子 量
- 43/101kDa
- 细胞定位
- 细胞核 细胞浆
- 性 状
- Lyophilized or Liquid
- 浓 度
- 1mg/ml
- 免 疫 原
- KLH conjugated Synthesised phosphopeptide derived from human Androgen Receptor around the phosphorylation site of Ser578:CG(p-S)C
- 亚 型
- IgG
- 纯化方法
- affinity purified by Protein A
- 储 存 液
- 0.01M TBS(pH7.4) with 1% BSA, 0.03% Proclin300 and 50% Glycerol.
- 保存条件
- Store at -20 °C for one year. Avoid repeated freeze/thaw cycles. The lyophilized antibody is stable at room temperature for at least one month and for greater than a year when kept at -20°C. When reconstituted in sterile pH 7.4 0.01M PBS or diluent of antibody the antibody is stable for at least two weeks at 2-4 °C.
- PubMed
- PubMed
- 产品介绍
- background:
The androgen receptor gene is more than 90 kb long and codes for a protein that has 3 major functional domains: the N-terminal domain, DNA-binding domain, and androgen-binding domain. The protein functions as a steroid-hormone activated transcription factor. Upon binding the hormone ligand, the receptor dissociates from accessory proteins, translocates into the nucleus, dimerizes, and then stimulates transcription of androgen responsive genes. This gene contains 2 polymorphic trinucleotide repeat segments that encode polyglutamine and polyglycine tracts in the N-terminal transactivation domain of its protein. Expansion of the polyglutamine tract causes spinal bulbar muscular atrophy (Kennedy disease). Mutations in this gene are also associated with complete androgen insensitivity (CAIS). Two alternatively spliced variants encoding distinct isoforms have been described. [provided by RefSeq, Jul 2008]
Function:
Steroid hormone receptors are ligand-activated transcription factors that regulate eukaryotic gene expression and affect cellular proliferation and differentiation in target tissues. Transcription factor activity is modulated by bound coactivator and corepressor proteins. Transcription activation is down-regulated by NR0B2. Activated, but not phosphorylated, by HIPK3 and ZIPK/DAPK3. [ENZYME REGULATION] AIM-100 (4-amino-5,6-biaryl-furo[2,3-d]pyrimidine) suppresses TNK2-mediated phosphorylation at Tyr-267. Inhibits the binding of the Tyr-267 phosphorylated form to androgen-responsive enhancers (AREs) and its transcriptional activity.
Subunit:
Binds DNA as a homodimer. Part of a ternary complex containing AR, EFCAB6/DJBP and PARK7. Interacts with HIPK3 and NR0B2 in the presence of androgen. The ligand binding domain interacts with KAT7/HBO1 in the presence of dihydrotestosterone. Interacts with EFCAB6/DJBP, PELP1, PQBP1, RANBP9, RBAK, SPDEF, SRA1, TGFB1I1, ZNF318 and RREB1. Interacts with ZMIZ1/ZIMP10 and ZMIZ2/ZMIP7 which both enhance its transactivation activity. Interacts with SLC30A9 and RAD54L2/ARIP4. Interacts via the ligand-binding domain with LXXLL and FXXLF motifs from NCOA1, NCOA2, NCOA3, NCOA4 and MAGEA11. The AR N-terminal poly-Gln region binds Ran resulting in enhancement of AR-mediated transactivation. Ran-binding decreases as the poly-Gln length increases. Interacts with HIP1 (via coiled coil domain). Interacts (via ligand-binding domain) with TRIM68. Interacts with TNK2. Interacts with USP26. Interacts with RNF6. Interacts (regulated by RNF6 probably through polyubiquitination) with RNF14; regulates AR transcriptional activity. Interacts with PRMT2 and TRIM24. Interacts with GNB2L1/RACK1. Interacts with RANBP10; this interaction enhances dihydrotestosterone-induced AR transcriptional activity. Interacts with PRPF6 in a hormone-independent way; this interaction enhances dihydrotestosterone-induced AR transcriptional activity. Interacts with STK4/MST1. Interacts with ZIPK/DAPK3. Interacts with LPXN. Interacts with MAK. Part of a complex containing AR, MAK and NCOA3.
Subcellular Location:
Nucleus. Cytoplasm. Note=Predominantly cytoplasmic in unligated form but translocates to the nucleus upon ligand-binding. Can also translocate to the nucleus in unligated form in the presence of GNB2L1.
Tissue Specificity:
Isoform 2 is mainly expressed in heart and skeletal muscle.
Post-translational modifications:
Sumoylated on Lys-386 (major) and Lys-520. Ubiquitinated. Deubiquitinated by USP26. Lys-6 and Lys-27-linked polyubiquitination by RNF6 modulates AR transcriptional activity and specificity.
Phosphorylated in prostate cancer cells in response to several growth factors including EGF. Phosphorylation is induced by c-Src kinase (CSK). Tyr-534 is one of the major phosphorylation sites and an increase in phosphorylation and Src kinase activity is associated with prostate cancer progression. Phosphorylation by TNK2 enhances the DNA-binding and transcriptional activity and may be responsible for androgen-independent progression of prostate cancer. Phosphorylation at Ser-81 by CDK9 regulates AR promoter selectivity and cell growth. Phosphorylation by PAK6 leads to AR-mediated transcription inhibition.
Palmitoylated by ZDHHC7 and ZDHHC21. Palmitoylation is required for plasma membrane targeting and for rapid intracellular signaling via ERK and AKT kinases and cAMP generation.
DISEASE:
Defects in AR are the cause of androgen insensitivity syndrome (AIS) [MIM:300068]; previously known as testicular feminization syndrome (TFM). AIS is an X-linked recessive form of pseudohermaphroditism due end-organ resistance to androgen. Affected males have female external genitalia, female breast development, blind vagina, absent uterus and female adnexa, and abdominal or inguinal testes, despite a normal 46,XY karyotype.
Defects in AR are the cause of spinal and bulbar muscular atrophy X-linked type 1 (SMAX1) [MIM:313200]; also known as Kennedy disease. SMAX1 is an X-linked recessive form of spinal muscular atrophy. Spinal muscular atrophy refers to a group of neuromuscular disorders characterized by degeneration of the anterior horn cells of the spinal cord, leading to symmetrical muscle weakness and atrophy. SMAX1 occurs only in men. Age at onset is usually in the third to fifth decade of life, but earlier involvement has been reported. It is characterized by slowly progressive limb and bulbar muscle weakness with fasciculations, muscle atrophy, and gynecomastia. The disorder is clinically similar to classic forms of autosomal spinal muscular atrophy. Note=Caused by trinucleotide CAG repeat expansion. In SMAX1 patients the number of Gln ranges from 38 to 62. Longer expansions result in earlier onset and more severe clinical manifestations of the disease.
Note=Defects in AR may play a role in metastatic prostate cancer. The mutated receptor stimulates prostate growth and metastases development despite of androgen ablation. This treatment can reduce primary and metastatic lesions probably by inducing apoptosis of tumor cells when they express the wild-type receptor.
Defects in AR are the cause of androgen insensitivity syndrome partial (PAIS) [MIM:312300]; also known as Reifenstein syndrome. PAIS is characterized by hypospadias, hypogonadism, gynecomastia, genital ambiguity, normal XY karyotype, and a pedigree pattern consistent with X-linked recessive inheritance. Some patients present azoospermia or severe oligospermia without other clinical manifestations.
Similarity:
Belongs to the nuclear hormone receptor family. NR3 subfamily.
Contains 1 nuclear receptor DNA-binding domain.
SWISS:
P10275
Gene ID:
367
Database links:Entrez Gene: 367Human
Entrez Gene: 11835Mouse
Entrez Gene: 24208Rat
Omim: 313700Human
SwissProt: P10275Human
SwissProt: P19091Mouse
SwissProt: P15207Rat
Unigene: 496240Human
Unigene: 39005Mouse
Unigene: 394224Mouse
Unigene: 439657Mouse
Unigene: 9813Rat
Important Note:
This product as supplied is intended for research use only, not for use in human, therapeutic or diagnostic applications.
类固醇受体(Steroid Receptors)
AR是一个由920个氨基酸组成的蛋白质,位于雄激素靶组织细胞中或细胞表面上的特异分子部位或结构。
AR在前列腺癌中起着重要的作用,研究表明AR的表达与组织分型形成一定的相关性 ,AR在高分化的肿瘤中表达较多,而在低分化的肿瘤中表达较少。用于前列腺癌的检测,指导临床治疗,目前可用于乳腺癌、食道癌等各项肿瘤的研究。
- 产品图片
 Sample:
Sample:
Muscle (Mouse) Lysate at 40 ug
Uterus (Mouse) Lysate at 40 ug
Ovary (Rat) Lysate at 40 ug
DU145(Human)Cell Lysate at 40 ug
Primary: Anti-phospho-Androgen Receptor (Ser578) (bs-0943R) at 1/300 dilution
Secondary: IRDye800CW Goat Anti-Rabbit IgG at 1/20000 dilution
Predicted band size: 101 kD
Observed band size: 101 kD Tissue/cell: human prostate tissue; 4% Paraformaldehyde-fixed and paraffin-embedded;
Tissue/cell: human prostate tissue; 4% Paraformaldehyde-fixed and paraffin-embedded;
Antigen retrieval: citrate buffer ( 0.01M, pH 6.0 ), Boiling bathing for 15min; Block endogenous peroxidase by 3% Hydrogen peroxide for 30min; Blocking buffer (normal goat serum,C-0005) at 37℃ for 20 min;
Incubation: Anti-AIS Polyclonal Antibody, Unconjugated(bs-0943R) 1:500, overnight at 4°C, followed by conjugation to the secondary antibody(SP-0023) and DAB(C-0010) staining Tissue/cell: human prostate tissue; 4% Paraformaldehyde-fixed and paraffin-embedded;
Tissue/cell: human prostate tissue; 4% Paraformaldehyde-fixed and paraffin-embedded;
Antigen retrieval: citrate buffer ( 0.01M, pH 6.0 ), Boiling bathing for 15min; Block endogenous peroxidase by 3% Hydrogen peroxide for 30min; Blocking buffer (normal goat serum,C-0005) at 37℃ for 20 min;
Incubation: Anti-phospho-Androgen Receptor(Ser580) Polyclonal Antibody, Unconjugated (bs-0943R) 1:200, overnight at 4°C, followed by conjugation to the secondary antibody(SP-0023) and DAB(C-0010) staining Blank control (Black line): U87MG (Black).
Blank control (Black line): U87MG (Black).
Primary Antibody (green line): Rabbit Anti-phospho-Androgen Receptor (Ser578) antibody (bs-0943R)
Dilution: 1μg /10^6 cells;
Isotype Control Antibody (orange line): Rabbit IgG .
Secondary Antibody (white blue line): Goat anti-rabbit IgG-AF647
Dilution: 1μg /test.
Protocol
The cells were fixed with 4% PFA (10min at room temperature)and then permeabilized with 90% ice-cold methanol for 20 min at room temperature. The cells were then incubated in 5%BSA to block non-specific protein-protein interactions for 30 min at room temperature .Cells stained with Primary Antibody for 30 min at room temperature. The secondary antibody used for 40 min at room temperature. Acquisition of 10,000 events was performed.

